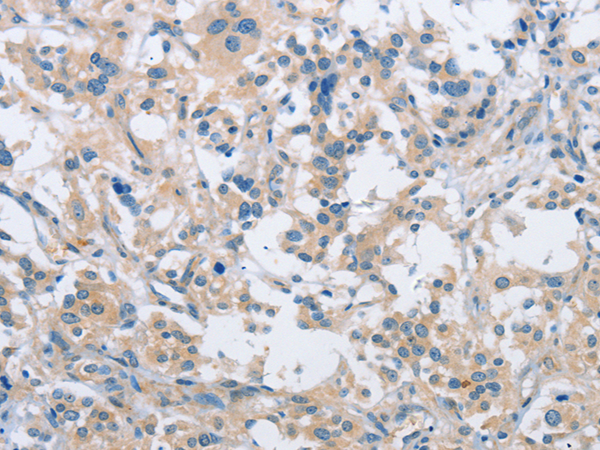

中文名稱:兔抗SH3GLB1多克隆抗體
英文名稱: Anti-SH3GLB1 rabbit polyclonal antibody
別 名: Bif-1; CGI-61; PPP1R70; dJ612B15.2
相關類別: 一抗
抗 原: SH3GLB1
儲 存: 冷凍(-20℃)
宿 主: Rabbit
反應種屬: Human, Mouse, Rat
標記物: Unconjugate
克隆類型: rabbit polyclonal
Background:
This gene encodes a SRC homology 3 domain-containing protein. The encoded protein interacts with the proapoptotic member of the Bcl-2 family, Bcl-2-associated X protein (Bax) and may be involved in regulating apoptotic signaling pathways. This protein may also be involved in maintaining mitochondrial morphology. Alternate splicing results in multiple transcript variants.
Applications:
ELISA, WB, IHC
Name of antibody:
SH3GLB1
Immunogen:
Fusion protein of human SH3GLB1
Full name:
SH3-domain GRB2-like endophilin B1
Synonyms:
Bif-1; CGI-61; PPP1R70; dJ612B15.2
SwissProt:
Q9Y371
IHC positive control:
Human gastric cancer and human thyroid cancer
IHC Recommend dilution:
15-50
WB Predicted band size:
41 kDa
WB Positive control:
Mouse heart tissue lysate
WB Recommended dilution:
200-1000
技術規(guī)格

購物車
購物車 幫助
幫助
 021-54845833/15800441009
021-54845833/15800441009
